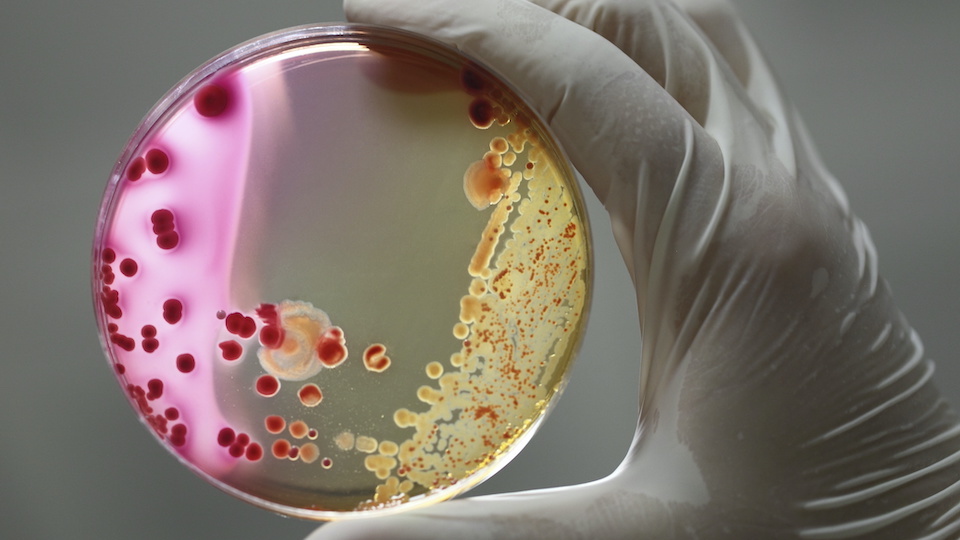

When foreign infectious pathogens like bacteria and viruses enter the body, your immune system produces antibodies to protect. So, the stronger your immune system is, the quicker it can produce antibodies. But for this to happen, you’ll need to incorporate some fairly easy “tricks” into your daily diet and routine — particularly during a time when coronavirus cases in the U.S. surpass four million, and deaths continue to surge. Here are some easy tricks that can help increase your natural antibodies.
Antibodies and your immune system
Antibodies are your own personal army, ready to fend off any foreign invaders entering your cells. This is especially important when it comes to viruses, like COVID-19, which enter human cells with a vengeance to replicate. It’s vital to have strong immunity since antibodies are proteins produced by the immune system. And while usually the body has an overabundance of antibodies — including very specific antibodies that target thousands of different pathogens — this can only happen with a healthy, normal-functioning immune system. Therefore, anything you can do to increase your natural defense benefits your health in a big way.
Cut down on fast and processed foods!
This seems like something that doesn’t bear repeating — over and over again. Yet, no matter how much solid information is out there, warning about the hazards of fast and processed foods, studies show that it’s most often the road travelled, leading Americans down a path to poor health, disease, and eventual death. But since we can’t see our immune systems at work, we rarely think about antibodies and the negative impact processed food has on a healthy immune system — until it’s too late.
This is really the simplest of all “tricks” to help increase immunity and antibodies. And it’s not really a trick; it’s just common sense. The nutrients you get from the food you eat, particularly those found in plant-based foods like veggies, fruits, herbs, and spices, are vital for your immune system to function correctly. And of course, eating plant-based does not mean you can’t eat meat. It simply means your meals consist largely of plant-based foods, like veggies, fruits, whole grains, beans, seeds, and nuts. According to The University of Texas, MD Anderson Cancer Center, the vitamins, minerals, antioxidants, and phytochemicals you get from plants help keep your immune system functioning optimally, cells healthy, and your body balanced.
Eat probiotic and prebiotic foods
No one food will magically build antibodies, but some foods can help protect your body from bacteria, viruses, and other germs from invading. Microbiome is a city in your body for trillions of microbes to live. While living primarily in the intestines, these microbes are both helpful and potentially harmful — but most live harmoniously together. According to Harvard T.H. Chan, School of Public Health, scientists are finding that the microbiome plays a big role in immune function. And since the gut is a major site for immune activity, it makes sense that feeding the gut the right nutrients not only helps strengthen immunity but also helps build antibodies. Probiotic foods have live bacteria that’s beneficial for your health, and prebiotic foods feed and maintain healthy colonies of those bacteria.
Probiotic foods include: Greek yogurt with live cultures, kefir, fermented vegetables like sauerkraut, kimchi and pickles, tempeh (fermented soy), kombucha tea, buttermilk, and miso.
Prebiotic foods include: Onions, garlic, leeks, Jerusalem artichokes, asparagus, dandelion greens, seaweed, and bananas. However, simply eating a variety of veggies, fruits, beans, and whole grains can supply you with essential prebiotics.
Walk for 10-minutes a few times a day
During your busy life, it may be hard to fit in an hour or two at the gym. But how about fitting in a 10-minute walk three times a day? Maybe that means jumping on the treadmill or parking in the furthest parking spot. Maybe that means taking 10 minutes after dinner for a walk around the block. Just walking for a total of 20 to 30 minutes a day can boost several defenses of the immune system. Research suggests that just a little daily exercise creates positive changes in antibodies and white blood cells (the body’s immune system cells that fight disease.) Exercise, it seems, gets antibodies and white blood cells moving faster and detecting illnesses earlier than they normally do. But keep your workouts moderate. High-intensity workouts, such as running a marathon might actually decrease the amount of white blood cells circulating through the body and up your chances of getting sick.
Limit your alcohol
With so many social activities revolving around wine and alcohol, it’s no wonder “wine time” has become a culture. “Come over for a cup of coffee” has morphed into “come over for a glass of wine.” But here’s the truth, while an occasional glass or two is fine — moderation is key, after all — drinking too much suppresses your immune system. Research published in the journal Clinical and Vaccine Immunology, suggests large amounts of alcohol suppresses the immune system. It seems alcohol consumption is toxic to immune system cells, playing a crucial role in immune function. This toxicity inhibits the ability of your antibodies to respond to danger signals, which creates a high risk for serious, and even life-threatening infections.
Reduce your stress levels
Only you know what works best for reducing your stress — quiet time listening to music, meditating, or going for a quiet walk in the park. Research suggests that your state of mind reflects your health. Stress weakens your immune system. However, managing stress, particularly chronic or long-term stress, even mild bouts, may help fight germs.
A recipe for success
Too many processed foods, high-stress lifestyles, and an obsession with alcohol leaves many people vulnerable to invading pathogens like bacteria and viruses. The best recipe for keeping your body safe from whatever ailments come your way is by keeping your immune system and antibodies fighting strong. And while it doesn’t take massive change to build strong antibodies, it does take a little common sense sprinkled with a healthy diet and a pinch of exercise.
-Katherine Marko